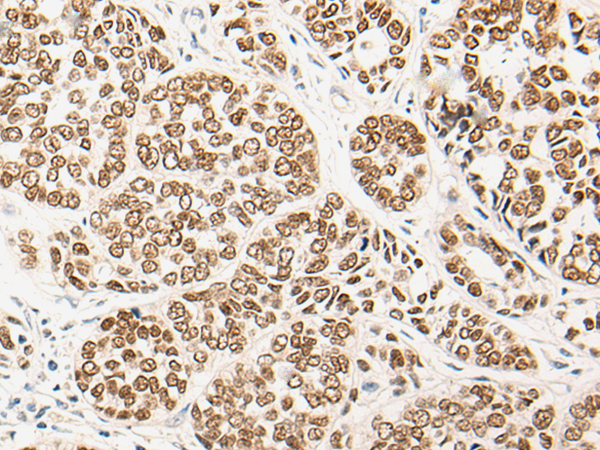
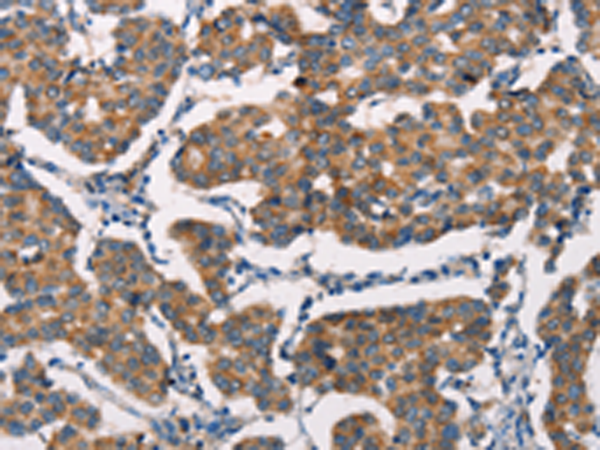
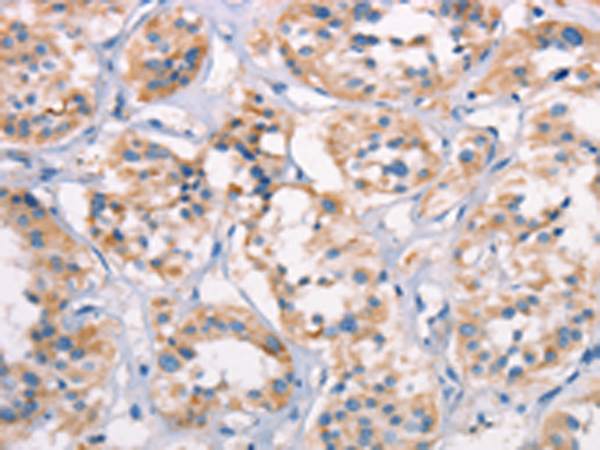

-
分类: 科研抗体货号: P11497别名: PKCB; PRKCB1; PRKCB2; PKC-beta应用: WB反应种属: Human, Mouse, Rat
-
分类: 科研抗体货号: P11533别名: AK6应用: WB反应种属: Human, Mouse
-
分类: 科研抗体货号: P11520别名: PEPCK1; PEPCKC; PEPCK-C应用: WB反应种属: Human, Mouse, Rat
-
分类: 科研抗体货号: P11531别名: SuPr-2应用: WB,IHC反应种属: Human
-
分类: 科研抗体货号: P11539别名: CMD1; SRA1; CMPD1应用: WB,IHC反应种属: Human, Mouse
-
分类: 科研抗体货号: P11518别名: Nek8; NERCC; NERCC1应用: IHC反应种属: Human, Mouse
-
分类: 科研抗体货号: P11530别名: KAT9应用: IHC反应种属: Human, Mouse
-
分类: 科研抗体货号: P11538别名: HALR; MLL3应用: IHC反应种属: Human, Mouse
-
分类: 科研抗体货号: P11551别名: HTR1C; 5-HT2C; 5HTR2C; 5-HTR2C应用: WB反应种属: Human, Mouse, Rat
-
分类: 科研抗体货号: P11529别名: SDR38C1应用: WB,IHC反应种属: Human, Mouse

鄂公网安备42018502007531号
鄂公网安备42018502007531号

